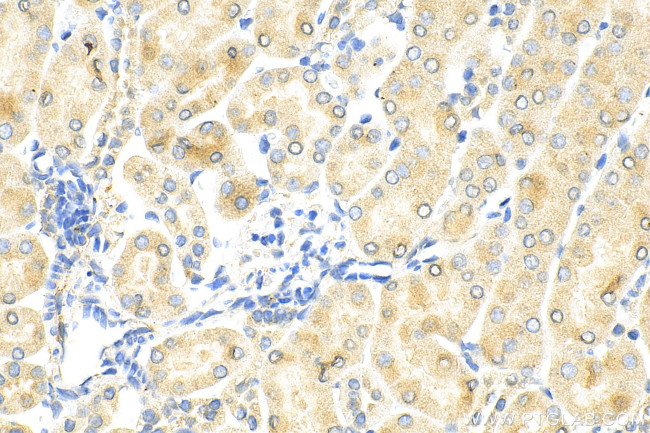
KIM-1/HAVCR1 Antibody in Immunohistochemistry (Paraffin) (IHC (P))

Search
Proteintech
KIM-1/HAVCR1 Polyclonal Antibody
{{$productOrderCtrl.translations['antibody.pdp.commerceCard.promotion.promotions']}}
{{$productOrderCtrl.translations['antibody.pdp.commerceCard.promotion.viewpromo']}}
{{$productOrderCtrl.translations['antibody.pdp.commerceCard.promotion.promocode']}}: {{promo.promoCode}} {{promo.promoTitle}} {{promo.promoDescription}}. {{$productOrderCtrl.translations['antibody.pdp.commerceCard.promotion.learnmore']}}
产品信息
30948-1-AP
种属反应
已发表种属
宿主/亚型
分类
类型
抗原
偶联物
形式
浓度
规格
纯化类型
保存液
内含物
保存条件
运输条件
靶标信息
CD365 also known as T-cell immunoglobulin and mucin domain 1 (Tim-1) is a type 1 surface glycoprotein that consists of extracellular N-terminal immunoglobulin V-like domain and a mucin domain, and a short cytoplasmic tail. The endogenous ligand for CD365 is Tim-4. In addition, CD365 is known to be a cellular receptor or co-receptor for a number of viruses including hepatitis A and C viruses, Ebola virus, Marburg virus, Dengue virus, Zika virus, West Nile virus, and Japanese encephalitis virus. The direct binding of the viruses by CD365 occurs via phosphatildyl-serine exposed on viral envelopes. Polymorphisms within human CD365 gene (HAVCR1) are associated with susceptibility to infection and the disease severity. CD365 has also been implicated in the T cell co-stimulation. CD365 is primarily expressed in epithelial cells. It is also highly expressed in A549, 769-P and Caco-2 and cell lines. CD365 exists also as a soluble protein generated by metalloproteinase mediated proteolytic cleavage of the surface protein.
仅用于科研。不用于诊断过程。未经明确授权不得转售。
生物信息学
蛋白别名: CD365; HAVcr-1; Hepatitis A virus cellular receptor 1 homolog; Kidney injury molecule 1; KIM-1; T cell immunoglobulin and mucin domain-containing protein 1; T cell membrane protein 1; T-cell immunoglobulin and mucin domain containing 1; T-cell immunoglobulin mucin receptor 1; TIM-1; TIMD-1
基因别名: AI503787; Havcr1; KIM-1; Kim1; TIM-1; Tim1; Timd1
UniProt ID: (Rat) O54947, (Mouse) Q7TPU2
Entrez Gene ID: (Rat) 286934, (Mouse) 171283